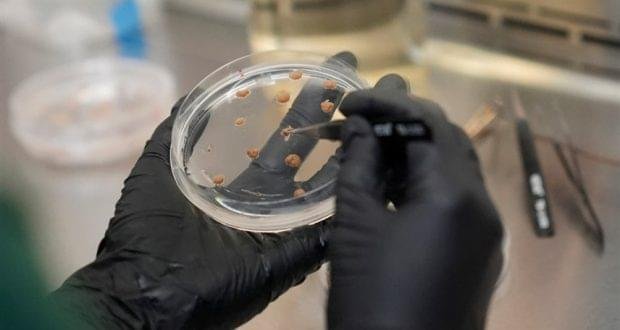

في ظل ازدياد الطلب العالمي على منتجات الكاكاو، والمتغيرات المناخية التي تضرب الغابات الاستوائية مصدر حبوب الكاكاو، لجأت شركة أمريكية إلى زراعة الكاكاو في المختبرات بدلاً من الغابات.
كشفت شركة “كاليفورنيا كالتشرد” المتخصصة في زراعة الخلايا النباتية، أنها بدأت بزراعة الكاكاو من مزارعها الخاصة غرب مدينة ساكرامنتو، آملة أن تصبح جاهزة للبيع منتصف العام المقبل.
شرح الرئيس التنفيذي للشركة آلان بيرلستين طريقة زراعة حبوب الكاكاو داخل مختبراته، مشيراً إلى أنها تبدأ باستخراج خلايا حبوب الكاكاو الأصلية، ثم وضعها في وعاء مائي مُحلّى بالسكر حتى تتكاثر بسرعة.
وأوضح في تصريح نقلته صحيفة “إندبندنت” البريطانية أن عملية نضج الخلايا لا تستغرق أكثر من أسبوع، فيما حصاد الكاكاو الطبيعي يحتاج إلى ما بين 6 إلى 8 أشهر، وعمل شاق لا تتطلبه الطريقة الحديثة.

نفس الطعم وفوائد أكثر
اعتبر بيرلشتاين أن هذه الطريقة لا مثيل لها لتغطية الطلب المتزايد على الشوكولا، والذي لم تعد أشجار الكاكاو المتواجدة جنوب خط الاستواء في المناطق ذات الطقس الدافئ والأمطار الغزيرة، قادرة على تلبيته.
وتوقع أن يؤدي تغير المناخ إلى تجفيف الأرض نتيجة الحرارة الإضافية، لذلك ابتكر علماء الشركة هذه الطريقة، التي توفر بديلاً مهماً للشوكولا يحمل نفس الطعم وفوائد أكثر، إضافة إلى مرونة أكبر في تلبية طلبات السوق العالمي.

قدرة كبيرة على دعم السوق
وأشارت المديرة التنفيذية للشركة كارلا دي مارتن إلى العديد من رواد الأعمال يراهنون على نمو الطلب بشكل أسرع من نمو المتوفر من الكاكاو، ما وضع الشركات المنتجة في حيرة من أمرها للبحث عن مصدر يتدفق.
وأوضحت أن البدائل المصنوعة من الشوفان أو نبات الخروب المحمص أثبتت فشلها، لأنها لم تتمكن من الوصول إلى نكهة الشوكولا، ما أدى إلى ارتفاع سعر منتجات الكاكاو عالمياً خلال العام الماضي.
وأمام كل هذه المعضلات، ونتيجة عدم الاستقرار المحتمل لمنتجات الشوكولا عالمياً، جاء ابتكار “كاليفورنيا كالتشرد” لبديل الكاكاو، ليوفر القدرة على تغطية الطلب المتزايد على الشوكولا في الولايات المتحدة، أوروبا والعالم.

تجارب ناجحة وأخرى فاشلة
يأتي التوجه لإنتاج الكاكاو داخل الولايات المتحدة بعدما نجحت الشركة بالفعل في زراعة منتجات أخرى داخل المختبرات، ومنها “لحم الدجاج”.
كما يأتي بالتزامن مع امتلاء رفوف المتاجر الكبرى بخيارات من الوجبات الخفيفة التي يُقال إنها بديلة للشوكولا، لكنها تتعرض لانتقادات كبيرة بسبب عدم تشابه الطعم.

صحيفة خلف الكواليس موقع خلف الكواليس متخصص بالاخباري المحليه أول بأول